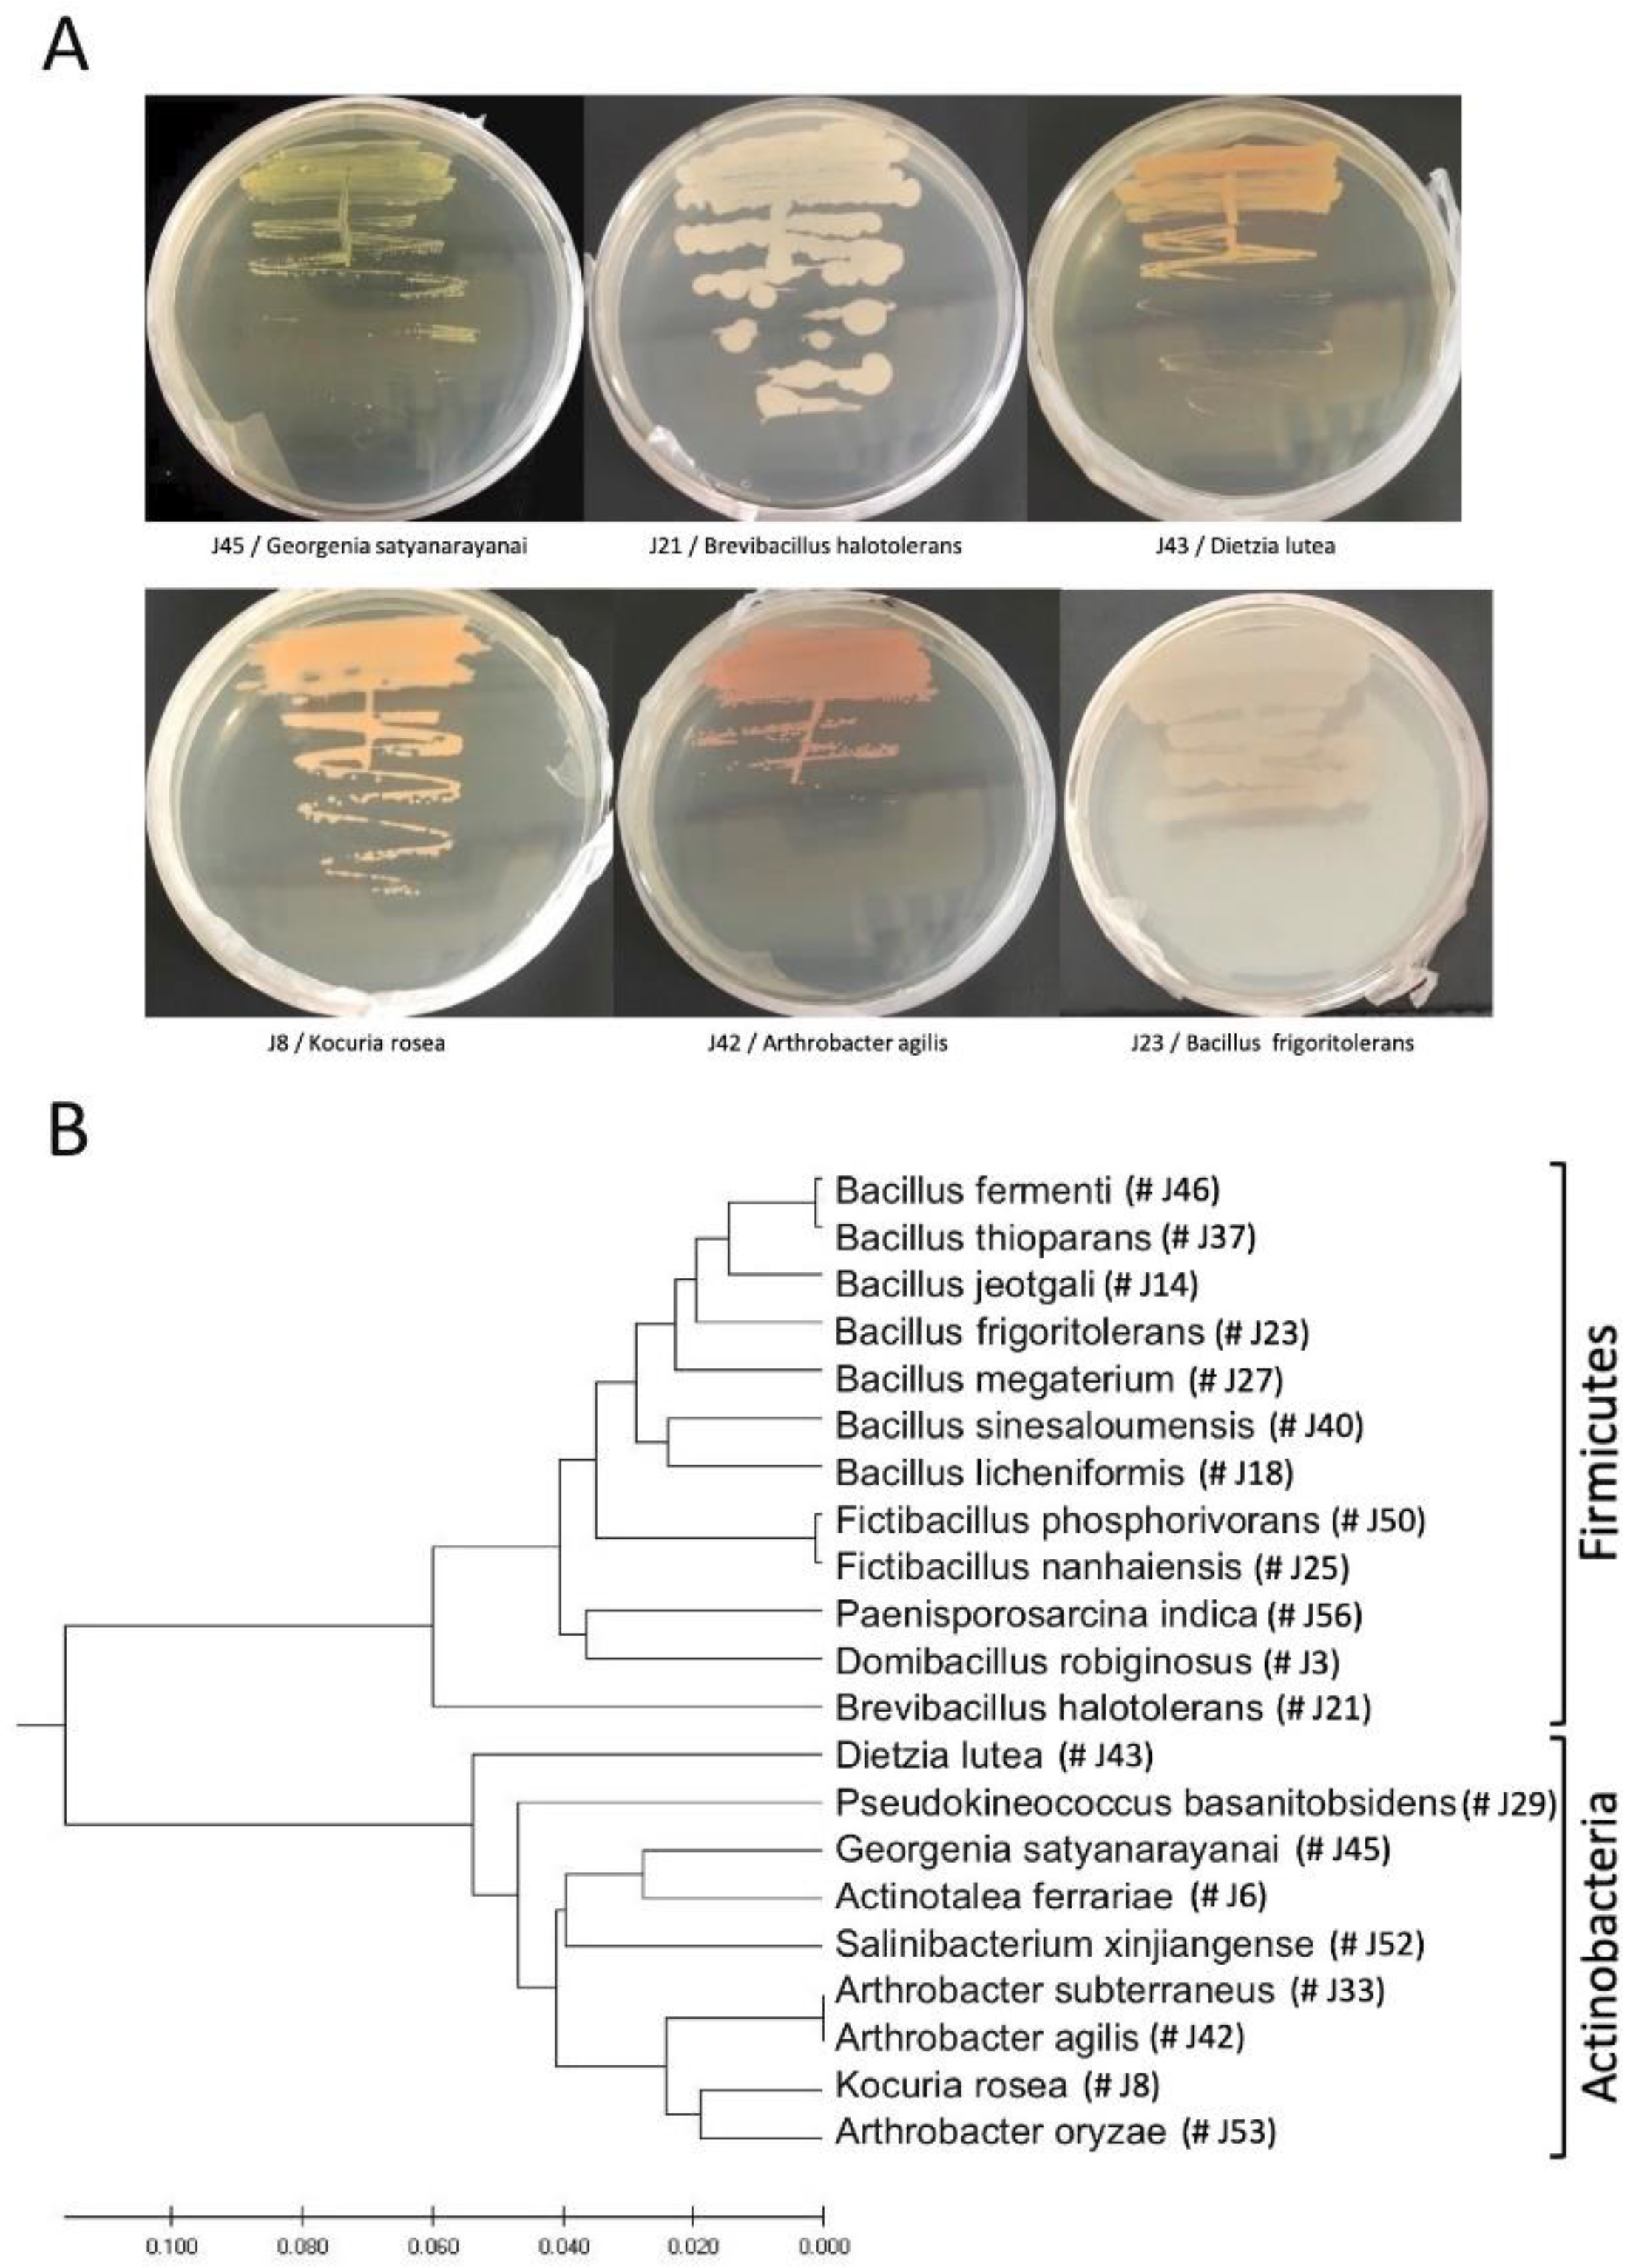
Plants 11 00484 g002

Endophytic Bacteria Colonizing the Petiole of the Desert Plant Zygophyllum dumosum Boiss: Possible Role in Mitigating Stress
Abstract
1. Introduction
2. Materials and Methods
2.1. Petiole Collection for Isolation of Endophytes and Preparation of Extracts
2.2. Isolation and Identification of Endophytic Bacteria from Petioles
2.3. Bacterial Growth in the Presence of Petiole Extracts (PEs)
2.4. Analysis of Primary Metabolites from Bacteria
2.5. Nutrient Analysis
2.6. Statistical Analysis
3. Results
3.1. Cultivation of Endophytic Bacteria from Z. dumosum Petioles
3.2. Z. dumosum Petiole Extracts (PEs) Promote Endophytic Bacterial Growth
3.3. Metabolic Analysis of Endophytic Bacteria
3.4. Z. dumosum Petioles Have Increased Levels of Nutrients during the Dry Season
4. Discussion
5. Conclusions
Supplementary Materials
Author Contributions
Funding
Institutional Review Board Statement
Informed Consent Statement
Data Availability Statement
Acknowledgments
Conflicts of Interest
References
- Grafi, G.A. “Mille-feuilles” of stress tolerance in the desert plant Zygophyllum dumosum Boiss.: Highlighting epigenetics. Isr. J. Plant Sci. 2019, 66, 52–59. [Google Scholar] [CrossRef]
- Noy-Meir, I. Desert ecosystems: Environment and producers. Annu. Rev. Ecol. Evol. Syst. 1973, 4, 25–51. [Google Scholar] [CrossRef]
- Bailey, H.P. Semi-Arid Climates: Their Definition and Distribution. In Agriculture in Semi-Arid Environments; Ecological Studies; Hall, A.E., Cannell, G.H., Lawton, H.W., Eds.; Springer: Berlin/Heidelberg, Germany, 1979; Volume 34, pp. 73–97. [Google Scholar]
- Khadka, J.; Yadav, N.S.; Granot, G.; Grafi, G. Seasonal growth of Zygophyllum dumosum Boiss.: Summer dormancy is associated with loss of the permissive epigenetic marker dimethyl H3K4 and extensive reduction in proteins involved in basic cell functions. Plants 2018, 7, 59. [Google Scholar] [CrossRef] [PubMed]
- Granot, G.; Sikron-Persi, N.; Gaspan, O.; Florentin, A.; Talwara, S.; Paul, L.K.; Morgenstern, Y.; Granot, Y.; Grafi, G. Histone modifications associated with drought tolerance in the desert plant Zygophyllum dumosum Boiss. Planta 2009, 231, 27–34. [Google Scholar] [CrossRef]
- Wang, Y.; Dai, C.-C. Endophytes: A potential resource for biosynthesis, biotransformation, and biodegradation. Ann. Microbiol. 2011, 61, 207–215. [Google Scholar] [CrossRef]
- Khare, E.; Mishra, J.; Arora, N.K. Multifaceted interactions between endophytes and plant: Developments and prospects. Front. Microbiol. 2018, 9, 2732. [Google Scholar] [CrossRef]
- Bibi, F.; Yasir, M.; Song, G.C.; Lee, S.Y.; Chung, Y.R. Diversity and characterization of endophytic bacteria associated with tidal flat plants and their antagonistic effects on oomycetous plant pathogens. Plant Pathol. J. 2012, 28, 20–31. [Google Scholar] [CrossRef][Green Version]
- Brunda, K.S.; Jahagirdar, S.; Kambrekar, D.N. Antagonistic activity of bacterial endophytes against major soil borne pathogens of soybean. J. Entomol. Zool. Stud. 2018, 6, 43–46. [Google Scholar]
- Chakraborty, U.; Roy, S.; Chakraborty, B. Microorganisms aiding existence and efficiency of plants in saline environment: What we know and what to expect. In Microorganisms in Saline Environments: Strategies and Functions; Giri, B., Varma, A., Eds.; Springer: Cham, Switzerland, 2019; Volume 56, pp. 211–235. [Google Scholar]
- Wang, X.; Cai, M.; Zhou, Y. Biological influence of cry1Ab gene insertion on the endophytic bacteria community in transgenic rice. Turk. J. Biol. 2018, 42, 231–239. [Google Scholar]
- Zhao, S.; Zhou, N.; Zhao, Z.Y.; Zhang, K.; Wu, G.H.; Tian, C.Y. Isolation of endophytic plant growth-promoting bacteria associated with the halophyte Salicornia europaea and evaluation of their promoting activity under salt stress. Curr. Microbiol. 2016, 73, 574–581. [Google Scholar] [CrossRef]
- Clark, R.Á.; Zeto, S.K. Mineral acquisition by arbuscular mycorrhizal plants. J. Plant Nutr. 2000, 23, 867–902. [Google Scholar] [CrossRef]
- Chhabra, S.; Dowling, D.N. Endophyte-promoted nutrient acquisition: Phosphorus and iron. In Functional Importance of the Plant Microbiome; Doty, S.L., Ed.; Springer: Cham, Switzerland, 2017; pp. 21–42. [Google Scholar]
- Nejad, P.; Johnson, P.A. Endophytic bacteria induce growth promotion and wilt disease suppression in oilseed rape and tomato. Biol. Control 2000, 18, 208–215. [Google Scholar] [CrossRef]
- Mohamad, O.A.A.; Li, L.; Ma, J.B.; Hatab, S.; Xu, L.; Guo, J.W.; Rasulov, B.A.; Liu, Y.H.; Hedlund, B.P.; Li, W.J. Evaluation of the antimicrobial activity of endophytic bacterial populations from chinese traditional medicinal plant licorice and characterization of the bioactive secondary metabolites produced by Bacillus atrophaeus against Verticillium dahliae. Front. Microbiol. 2018, 9, 924. [Google Scholar] [CrossRef] [PubMed]
- Singh, M.; Kumar, A.; Singh, R.; Pandey, K.D. Endophytic bacteria: A new source of bioactive compounds. 3 Biotech 2017, 7, 315. [Google Scholar] [CrossRef] [PubMed]
- Cohen, A.C.; Travaglia, C.N.; Bottini, R.; Piccoli, P.N. Participation of abscisic acid and gibberellins produced by endophytic Azospirillum in the alleviation of drought effects in maize. Botany 2009, 87, 455–462. [Google Scholar] [CrossRef]
- Kaplan, D.; Maymon, M.; Agapakis, C.M.; Lee, A.; Wang, A.; Prigge, B.A.; Volkogon, M.; Hirsch, A.M. A survey of the microbial community in the rhizosphere of two dominant shrubs of the Negev Desert highlands, Zygophyllum dumosum (Zygophyllaceae) and Atriplex halimus (Amaranthaceae), using cultivation-dependent and cultivation-independent methods. Am. J. Bot. 2013, 100, 1713–1725. [Google Scholar] [CrossRef]
- Vonshak, A.; Sklarz, M.Y.; Hirsch, A.M.; Gillor, O. Perennials but not slope aspect affect the diversity of soil bacterial communities in the northern Negev Desert, Israel. Soil Res. 2018, 56, 123. [Google Scholar] [CrossRef]
- Liu, H.-Q.; Lu, X.-B.; Li, Z.-H.; Tian, C.-Y.; Song, J. The role of root-associated microbes in growth stimulation of plants under saline conditions. Land Degrad. Dev. 2021, 32, 3471–3486. [Google Scholar] [CrossRef]
- Maymon, M.; Martínez-Hidalgo, P.; Tran, S.S.; Ice, T.; Craemer, K.; Anbarchian, T.; Sung, T.; Hwang, L.H.; Chou, M.; Fujishige, N.A.; et al. Mining the phytomicrobiome to understand how bacterial coinoculations enhance plant growth. Front. Plant Sci. 2015, 6, 784. [Google Scholar] [CrossRef]
- Khan, N.; Martínez-Hidalgo, P.; Humm, E.A.; Maymon, M.; Kaplan, D.; Hirsch, A.M. Inoculation with a microbe isolated from the Negev Desert enhances corn growth. Front. Microbiol. 2020, 11, 1149. [Google Scholar] [CrossRef]
- Finkel, O.M.; Delmont, T.O.; Post, A.F.; Belkin, S. Metagenomic signatures of bacterial adaptation to life in the phyllosphere of a salt-secreting desert tree. Appl. Environ. Microbiol. 2016, 82, 2854–2861. [Google Scholar] [CrossRef] [PubMed]
- Jain, R.; Bhardwaj, P.; Pandey, S.S.; Kumar, S. Arnebia euchroma, a plant species of cold desert in the Himalayas, harbors beneficial cultivable endophytes in roots and leaves. Front. Microbiol. 2021, 12, 696667. [Google Scholar] [CrossRef] [PubMed]
- Massimo, N.C.; Nandi Devan, M.M.; Arendt, K.R.; Wilch, M.H.; Riddle, J.M.; Furr, S.H.; Steen, C.; U’Ren, J.M.; Sandberg, D.C.; Arnold, A.E. Fungal endophytes in aboveground tissues of desert plants: Infrequent in culture, but highly diverse and distinctive symbionts. Microb. Ecol. 2015, 70, 61–76. [Google Scholar] [CrossRef]
- Zhang, Q.; Acuña, J.J.; Inostroza, N.G.; Mora, M.L.; Radic, S.; Sadowsky, M.J.; Jorquera, M.A. Endophytic bacterial communities associated with roots and leaves of plants growing in Chilean extreme environments. Sci. Rep. 2019, 9, 4950. [Google Scholar] [CrossRef] [PubMed]
- Eida, A.A.; Ziegler, M.; Lafi, F.F.; Michell, C.T.; Voolstra, C.R.; Hirt, H.; Saad, M.M. Desert plant bacteria reveal host influence and beneficial plant growth properties. PLoS ONE 2018, 13, e0208223. [Google Scholar] [CrossRef]
- de Lillo, A.; Ashley, F.P.; Palmer, R.M.; Munson, M.A.; Kyriacou, L.; Weightman, A.J.; Wade, W.G. Novel subgingival bacterial phylotypes detected using multiple universal polymerase chain reaction primer sets. Oral Microbiol. Immunol. 2006, 21, 61–68. [Google Scholar] [CrossRef]
- Reshef, N.; Fait, A.; Agam, N. Grape berry position affects the diurnal dynamics of its metabolic profile. Plant Cell Environ. 2019, 42, 1897–1912. [Google Scholar] [CrossRef]
- Li, Y.; Chen, F.; Dong, K.; Wang, G. Actinotalea ferrariae sp. nov., isolated from an iron mine, and emended description of the genus Actinotalea. Int. J. Syst. Evol. 2013, 633, 398–3403. [Google Scholar] [CrossRef]
- Velázquez-Becerra, C.; Macías-Rodríguez, L.I.; López-Bucio, J.; Flores-Cortez, I.; Santoyo, G.; Hernández-Soberano, C.; Valencia-Cantero, E. The rhizobacterium Arthrobacter agilis produces dimethylhexadecylamine, a compound that inhibits growth of phytopathogenic fungi in vitro. Protoplasma 2013, 250, 1251–1262. [Google Scholar] [CrossRef]
- Ramírez-Ordorica, A.; Valencia-Cantero, E.; Flores-Cortez, I.; Carrillo-Rayas, M.T.; Elizarraraz-Anaya, M.; Montero-Vargas, J.; Winkler, R.; Macías-Rodríguez, L. Metabolomic effects of the colonization of Medicago truncatula by the facultative endophyte Arthrobacter agilis UMCV2 in a foliar inoculation system. Sci. Rep. 2020, 10, 8426. [Google Scholar] [CrossRef]
- Kageyama, A.; Morisaki, K.; Omura, S.; Takahashi, Y. Arthrobacter oryzae sp. nov. and Arthrobacter humicola sp. nov. Int. J. Syst. Evol. Microbiol. 2008, 58, 53–56. [Google Scholar] [CrossRef] [PubMed]
- Chang, H.W.; Bae, J.W.; Nam, Y.D.; Kwon, H.Y.; Park, J.R.; Shin, K.S.; Kim, K.H.; Quan, Z.X.; Rhee, S.K.; An, K.G.; et al. Arthrobacter subterraneus sp. nov., isolated from deep subsurface water of the South Coast of Korea. J. Microbiol. Biotechnol. 2007, 17, 1875–1879. [Google Scholar] [PubMed]
- Srinivas, A.; Rahul, K.; Sasikala, C.; Subhash, Y.; Ramaprasad, E.; Ramana, C.V. Georgenia satyanarayanai sp. nov., an alkaliphilic and thermotolerant amylase-producing actinobacterium isolated from a soda lake. Int. J. Syst. Evol. Microbiol. 2012, 62, 2405–2409. [Google Scholar] [CrossRef] [PubMed]
- Schwabe, R.; Dittrich, C.; Kadner, J.; Rudi Senges, C.H.; Bandow, J.E.; Tischler, D.; Schlömann, M.; Levicán, G.; Wiche, O. Secondary metabolites released by the rhizosphere bacteria Arthrobacter oxydans and Kocuria rosea enhance plant availability and soil-plant transfer of germanium (Ge) and rare earth elements (REEs). Chemosphere 2021, 285, 131466. [Google Scholar] [CrossRef] [PubMed]
- Lee, D.W.; Park, M.Y.; Kim, J.-J.; Kim, B.S. Pseudokineococcus basanitobsidens sp. nov., isolated from volcanic rock. Int. J. Syst. Evol. Microbiol. 2017, 67, 3824–3828. [Google Scholar] [CrossRef]
- Zhang, D.C.; Liu, H.C.; Xin, Y.H.; Yu, Y.; Zhou, P.J.; Zhou, Y.G. Salinibacterium xinjiangense sp. nov., a psychrophilic bacterium isolated from the China No. 1 glacier. Int. J. Syst. Evol. Microbiol. 2008, 58, 2739–2742. [Google Scholar] [CrossRef]
- Hirota, K.; Nishita, M.; Tu, Z.; Matsuyama, H.; Yumoto, I. Bacillus fermenti sp. nov., an indigo-reducing obligate alkaliphile isolated from indigo fermentation liquor for dyeing. Int. J. Syst. Evol. Microbiol. 2018, 68, 1123–1129. [Google Scholar] [CrossRef]
- Zhang, C.; Li, X.; Yin, L.; Liu, C.; Zou, H.; Wu, Z.; Zhang, Z. Analysis of the complete genome sequence of Brevibacterium frigoritolerans ZB201705 isolated from drought- and salt-stressed rhizosphere soil of maize. Ann. Microbiol. 2019, 69, 1489–1496. [Google Scholar] [CrossRef]
- Liu, G.H.; Liu, B.; Wang, J.P.; Che, J.M.; Li, P.F. Reclassification of Brevibacterium frigoritolerans DSM 8801T as Bacillus frigoritolerans comb. nov. Based on Genome Analysis. Curr. Microbiol. 2020, 77, 1916–1923. [Google Scholar] [CrossRef]
- Yoon, J.H.; Kang, S.S.; Lee, K.C.; Kho, Y.H.; Choi, S.H.; Kang, K.H.; Park, Y.H. Bacillus jeotgali sp. nov., isolated from jeotgal, Korean traditional fermented seafood. Int. J. Syst. Evol. Microbiol. 2001, 51, 1087–1092. [Google Scholar] [CrossRef]
- Muras, A.; Romero, M.; Mayer, C.; Otero, A. Biotechnological applications of Bacillus licheniformis. Crit. Rev. Biotechnol. 2021, 41, 609–627. [Google Scholar] [CrossRef] [PubMed]
- Vary, P.S.; Biedendieck, R.; Fuerch, T.; Meinhardt, F.; Rohde, M.; Deckwer, W.D.; Jahn, D. Bacillus megaterium—From simple soil bacterium to industrial protein production host. Appl. Microbiol. Biotechnol. 2007, 76, 957–967. [Google Scholar] [CrossRef] [PubMed]
- Sarr, M.; Lo, C.I.; Tall, M.L.; Fadlane, A.; Senghor, B.; Sokhna, C.; Raoult, D.; Million, M.; Fenollar, F. Taxonogenomics description of Bacillus dakarensis sp. nov., Bacillus sinesaloumensis sp. nov. and Bacillus massiliogabonensis sp. nov., three new species isolated from human stools. New Microbes New Infect. 2020, 37, 100718. [Google Scholar] [CrossRef] [PubMed]
- Rodríguez-Tirado, V.; Green-Ruiz, C.; Gómez-Gil, B. Cu and Pb biosorption on Bacillus thioparans strain U3 in aqueous solution: Kinetic and equilibrium studies. Chem. Eng. J. 2012, 181–182, 352–359. [Google Scholar] [CrossRef]
- Song, J.; Wang, Y.; Song, Y.; Zhao, B.; Wang, H.; Zhou, S.; Kong, D.; Guo, X.; Li, Y.; He, M.; et al. Brevibacillus halotolerans sp. nov., isolated from saline soil of a paddy field. Int. J. Syst. Evol. Microbiol. 2017, 67, 772–777. [Google Scholar] [CrossRef] [PubMed]
- Seiler, H.; Wenning, M.; Scherer, S. Domibacillus robiginosus gen. nov., sp. nov., isolated from a pharmaceutical clean room. Int. J. Syst. Evol. Microbiol 2013, 63, 2054–2061. [Google Scholar] [CrossRef]
- Glaeser, S.P.; Dott, W.; Busse, H.-J.; Kämpfer, P. Fictibacillus phosphorivorans gen. nov., sp. nov. and proposal to reclassify Bacillus arsenicus, Bacillus barbaricus, Bacillus macauensis, Bacillus nanhaiensis, Bacillus rigui, Bacillus solisalsi and Bacillus gelatini in the genus Fictibacillus. Int. J. Syst. Evol. Microbiol. 2013, 63, 2934–2944. [Google Scholar] [CrossRef]
- Reddy, G.S.N.; Manasa, B.P.; Singh, S.K.; Shivaji, S. Paenisporosarcina indica sp. nov., a psychrophilic bacterium from a glacier, and reclassification of Sporosarcina antarctica Yu et al., 2008 as Paenisporosarcina antarctica comb. nov. and emended description of the genus Paenisporosarcina. Int. J. Syst. Evol. Microbiol. 2013, 63, 2927–2933. [Google Scholar] [CrossRef]
- El Moukhtari, A.; Cabassa-Hourton, C.; Farissi, M.; Savouré, A. How does proline treatment promote salt stress tolerance during crop plant development? Front. Plant Sci. 2020, 11, 1127. [Google Scholar] [CrossRef]
- Fernandez, O.; Béthencourt, L.; Quero, A.; Sangwan, R.S.; Clément, C. Trehalose and plant stress responses: Friend or foe? Trends Plant Sci. 2010, 15, 409–417. [Google Scholar] [CrossRef]
- Kumar, A.; Bachhawat, A.K. Pyroglutamic acid: Throwing light on a lightly studied metabolite. Curr. Sci. 2012, 102, 288–297. [Google Scholar]
- Mendes, R.; Garbeva, P.; Raaijmakers, J.M. The rhizosphere microbiome: Significance of plant beneficial, plant pathogenic, and human pathogenic microorganisms. FEMS Microbiol. Rev. 2013, 37, 634–663. [Google Scholar] [CrossRef] [PubMed]
- Lindow, S.E.; Brandl, M.T. Microbiology of the phyllosphere. Appl. Environ. Microbiol. 2003, 69, 1875–1883. [Google Scholar] [CrossRef]
- Xie, W.Y.; Su, J.Q.; Zhu, Y.G. Phyllosphere bacterial community of floating macrophytes in paddy soil environments as revealed by illumina high-throughput sequencing. Appl. Environ. Microbiol. 2015, 81, 522–532. [Google Scholar] [CrossRef] [PubMed]
- Al-Awadhi, H.; Al-Mailem, D.; Dashti, N.; Hakam, L.; Eliyas, M.; Radwan, S. The abundant occurrence of hydrocarbon-utilizing bacteria in the phyllospheres of cultivated and wild plants in Kuwait. Int. Biodeterior. Biodegrad. 2012, 73, 73–79. [Google Scholar] [CrossRef]
- Qvit-Raz, N.; Jurkevitch, E.; Belkin, S. Drop-size soda lakes: Transient microbial habitats on a salt-secreting desert tree. Genetics 2008, 178, 1615–1622. [Google Scholar] [CrossRef] [PubMed]
- Favet, J.; Lapanje, A.; Giongo, A.; Kennedy, S.; Aung, Y.Y.; Cattaneo, A.; Davis-Richardson, A.G.; Brown, C.T.; Kort, R.; Brumsack, H.J.; et al. Microbial hitchhikers on intercontinental dust: Catching a lift in Chad. ISME J. 2013, 7, 850–867. [Google Scholar] [CrossRef]
- Eevers, N.; Gielen, M.; Sánchez-López, A.; Jaspers, S.; White, J.C.; Vangronsveld, J.; Weyens, N. Optimization of isolation and cultivation of bacterial endophytes through addition of plant extract to nutrient media. Microb. Biotechnol. 2015, 8, 707–715. [Google Scholar] [CrossRef]
- Puente, M.E.; Li, C.Y.; Bashan, Y. Endophytic bacteria in cacti seeds can improve the development of cactus seedlings. Environ. Exp. Bot. 2009, 66, 402–408. [Google Scholar] [CrossRef]
- Lopez, B.R.; Tinoco-Ojanguren, C.; Bacilio, M.; Mendoza, A.; Bashan, Y. Endophytic bacteria of the rock-dwelling cactus Mammillaria fraileana affect plant growth and mobilization of elements from rocks. Environ. Exp. Bot. 2012, 81, 26–36. [Google Scholar] [CrossRef]
- Eida, A.A.; Alzubaidy, H.S.; de Zélicourt, A.; Synek, L.; Alsharif, W.; Lafi, F.F.; Hirt, H.; Saad, M.M. Phylogenetically diverse endophytic bacteria from desert plants induce transcriptional changes of tissue-specific ion transporters and salinity stress in Arabidopsis thaliana. Plant Sci. 2019, 280, 228–240. [Google Scholar] [CrossRef] [PubMed]
- Eke, P.; Kumar, A.; Sahu, K.P.; Wakam, L.N.; Sheoran, N.; Ashajyothi, M.; Patel, A.; Fekam, F.B. Endophytic bacteria of desert cactus (Euphorbia trigonas Mill) confer drought tolerance and induce growth promotion in tomato (Solanum lycopersicum L.). Microbiol. Res. 2019, 228, 126302. [Google Scholar] [CrossRef] [PubMed]
- ALKahtani, M.D.; Fouda, A.; Attia, K.A.; Al-Otaibi, F.; Eid, A.M.; Ewais, E.E.; Hijri, M.; St-Arnaud, M.; Hassan, S.E.; Khan, N.; et al. Isolation and characterization of plant growth promoting endophytic bacteria from desert plants and their application as bioinoculants for sustainable agriculture. Agronomy 2020, 10, 1325. [Google Scholar] [CrossRef]
- Kushwaha, P.; Kashyap, P.L.; Bhardwaj, A.K.; Kuppusamy, P.; Srivastava, A.K.; Tiwari, R.K. Bacterial endophyte mediated plant tolerance to salinity: Growth responses and mechanisms of action. World J. Microbiol. Biotechnol. 2020, 36, 26. [Google Scholar] [CrossRef] [PubMed]
- Owen, N.L.; Hundley, N. Endophytes—The chemical synthesizers inside plants. Sci. Prog. 2004, 87, 79–99. [Google Scholar] [CrossRef] [PubMed]
- Martinez-Klimova, E.; Rodríguez-Peña, K.; Sánchez, S. Endophytes as sources of antibiotics. Biochem. Pharmacol. 2017, 134, 1–17. [Google Scholar] [CrossRef]
- Borah, M.; Das, S.; Bora, S.S.; Boro, R.C.; Barooah, M. Comparative assessment of multi-trait plant growth-promoting endophytes associated with cultivated and wild Oryza germplasm of Assam, India. Arch. Microbiol. 2021, 203, 2007–2028. [Google Scholar] [CrossRef]
- Loaces, I.; Ferrando, L.; Scavino, A.F. Dynamics, diversity and function of endophytic siderophore-producing bacteria in rice. Microb. Ecol. 2011, 61, 606–618. [Google Scholar] [CrossRef]
- Venil, C.K.; Zakaria, Z.A.; Ahmad, W.A. Bacterial pigments and their applications. Process Biochem. 2013, 48, 1065–1079. [Google Scholar] [CrossRef]
- Pavan, M.E.; López, N.I.; Pettinari, M.J. Melanin biosynthesis in bacteria, regulation and production perspectives. Appl. Microbiol. Biotechnol. 2020, 104, 1357–1370. [Google Scholar] [CrossRef]
- Mohammadi, M.; Burbank, L.; Roper, M.C. Biological role of pigment production for the bacterial phytopathogen Pantoea stewartii subsp. stewartii. Appl. Environ. Microbiol. 2012, 78, 6859–6865. [Google Scholar] [CrossRef] [PubMed]
- Pierson, L.S.; Pierson, E.A. Metabolism and function of phenazines in bacteria: Impacts on the behavior of bacteria in the environment and biotechnological processes. Appl. Microbiol. Biotechnol. 2010, 86, 1659–1670. [Google Scholar] [CrossRef] [PubMed]
- Montaner, B.; Prez-Toms, R. The prodigiosins: A new family of anticancer drugs. Curr. Cancer Drug Targets 2003, 70, 57–65. [Google Scholar] [CrossRef] [PubMed]
- Turner, J.M.; Messenger, A.J. Occurrence, biochemistry and physiology of phenazine pigment production. Adv. Microb. Physiol. 1986, 27, 211–275. [Google Scholar]
- Oren, A.; Rodríguez-Valera, F. The contribution of halophilic Bacteria to the red coloration of saltern crystallizer ponds. FEMS Microbiol. Ecol. 2001, 36, 123–130. [Google Scholar] [CrossRef]
- Soliev, A.B.; Hosokawa, K.; Enomoto, K. Bioactive pigments from marine bacteria: Applications and physiological roles. Evid. Based Complement. Alternat. Med. 2011, 2011, 670349. [Google Scholar] [CrossRef]
- Proteau, P.J.; Gerwick, W.H.; Garcia-Pichel, F.; Castenholz, R. The structure of scytonemin, an ultraviolet sunscreen pigment from the sheaths of cyanobacteria. Experientia 1993, 49, 825–829. [Google Scholar] [CrossRef]
- Rock, C.D.; Zeevaart, J.A. The aba mutant of Arabidopsis thaliana is impaired in epoxy-carotenoid biosynthesis. Proc. Natl. Acad. Sci. USA 1991, 88, 7496–7499. [Google Scholar] [CrossRef]
- Hashimoto, H.; Uragami, C.; Cogdell, R.J. Carotenoids and Photosynthesis. Subcell Biochem. 2016, 79, 111–139. [Google Scholar]
- Benaroudj, N.; Goldberg, A.L. Trehalose accumulation during cellular stress protects cells and cellular proteins from damage by oxygen radicals. J. Biol. Chem. 2001, 276, 24261–24267. [Google Scholar] [CrossRef]
- Iordachescu, M.; Imai, R. Trehalose biosynthesis in response to abiotic stresses. J. Integr. Plant Biol. 2008, 50, 1223–1229. [Google Scholar] [CrossRef] [PubMed]
- Drennan, P.M.; Smith, M.T.; Goldsworthy, D.; van Staden, J. The occurrence of trehalose in the leaves of the desiccation-tolerant angiosperm Myrothamnus flabellifolius welw. J. Plant Physiol. 1993, 142, 493–496. [Google Scholar] [CrossRef]
- Albini, F.M.; Murelli, C.; Patritti, G.; Rovati, M.; Zienna, P.; Vita Finzi, P. Low-molecular weight substances from the resurrection plant Sporobolus stapfianus. Phytochemistry 1994, 37, 137–142. [Google Scholar] [CrossRef]
- Bonini, B.M.; Van Dijck, P.; Thevelein, J.M. Trehalose metabolism: Enzymatic pathways and physiological functions. In Biochemistry and Molecular Biology; (The Mycota); Brambl, R., Marzluf, G.A., Eds.; Springer: Berlin/Heidelberg, Germany, 2004; Volume 3, pp. 291–319. [Google Scholar]
- Goddijn, O.J.; van Dun, K. Trehalose metabolism in plants. Trends Plant Sci. 1999, 4, 315–319. [Google Scholar] [CrossRef]
- Bohnert, H.J.; Jensen, R.G. Strategies for engineering water-stress tolerance in plants. Trends Biotechnol. 1996, 14, 89–97. [Google Scholar] [CrossRef]
- Biswas, S.; Biswas, A.K.; De, B. Influence of sodium chloride on growth and metabolic reprogramming in nonprimed and haloprimed seedlings of blackgram (Vigna mungo L.). Protoplasma 2020, 257, 1559–1583. [Google Scholar] [CrossRef]
- Hayat, S.; Hayat, Q.; Alyemeni, M.N.; Wani, A.S.; Pichtel, J.; Ahmad, A. Role of proline under changing environments: A review. Plant Signal Behav. 2012, 7, 1456–1466. [Google Scholar] [CrossRef]
- Szabados, L.; Savouré, A. Proline: A multifunctional amino acid. Trends Plant Sci. 2010, 15, 89–97. [Google Scholar] [CrossRef]
- Kaur, G.; Asthir, B.J.B.P. Proline: A key player in plant abiotic stress tolerance. Biol. Plant. 2015, 59, 609–619. [Google Scholar] [CrossRef]
- Verslues, P.E.; Sharma, S. Proline metabolism and its implications for plant-environment interaction. Arab. Book 2010, 8, e0140. [Google Scholar] [CrossRef]
- Rashid, U.; Yasmin, H.; Hassan, M.N.; Naz, R.; Nosheen, A.; Sajjad, M.; Ilyas, N.; Keyani, R.; Jabeen, Z.; Mumtaz, S.; et al. Drought-tolerant Bacillus megaterium isolated from semi-arid conditions induces systemic tolerance of wheat under drought conditions. Plant Cell Rep. 2021, 241, 1–21. [Google Scholar] [CrossRef] [PubMed]
- Evelin, H.; Devi, T.S.; Gupta, S.; Kapoor, R. Mitigation of salinity stress in plants by arbuscular mycorrhizal symbiosis: Current understanding and new challenges. Front. Plant Sci. 2019, 10, 470. [Google Scholar] [CrossRef] [PubMed]
- Szymańska, S.; Płociniczak, T.; Piotrowska-Seget, Z.; Hrynkiewicz, K. Endophytic and rhizosphere bacteria associated with the roots of the halophyte Salicornia europaea L.—Community structure and metabolic potential. Microbiol. Res. 2016, 192, 37–51. [Google Scholar] [CrossRef] [PubMed]
- Sikron-Persi, N.; Granot, G.; Grafi, G.; Fait, A. Accumulation of newly identified sulfur containing metabolites in Zygophyllum dumosum Boiss suggest for a role of secondary metabolism in petiole survival during the dry season. Isr. J. Plant Sci. 2019, 66, 94–102. [Google Scholar] [CrossRef]
- Bertoldo, G.; Della Lucia, M.C.; Squartini, A.; Concheri, G.; Broccanello, C.; Romano, A.; Ravi, S.; Cagnin, M.; Baglieri, A.; Stevanato, P. Endophytic microbiome responses to sulfur availability in Beta vulgaris (L.). Int. J. Mol. Sci. 2021, 22, 7184. [Google Scholar] [CrossRef]
- Hasanuzzaman, M.; Bhuyan, M.H.M.B.; Mahmud, J.A.; Nahar, K.; Mohsin, S.M.; Parvin, K.; Fujita, M. Interaction of sulfur with phytohormones and signaling molecules in conferring abiotic stress tolerance to plants. Plant Signal Behav. 2018, 13, e1477905. [Google Scholar] [CrossRef]
- Shen, Y.; Issakidis-Bourguet, E.; Zhou, D.X. Perspectives on the interactions between metabolism, redox, and epigenetics in plants. J. Exp. Bot. 2016, 67, 5291–5300. [Google Scholar] [CrossRef]
- Brader, G.; Compant, S.; Mitter, B.; Trognitz, F.; Sessitsch, A. Metabolic potential of endophytic bacteria. Curr. Opin. Biotechnol. 2014, 27, 30–37. [Google Scholar] [CrossRef]

| Strains | Identity % | Accession No | Source | Ref. | |
|---|---|---|---|---|---|
| Phylum | Species | ||||
| Actinobacteria | [J6] Actinotalea ferrariae | 98.99 | KT 021826.1 | Iron mine | [31] |
| [J42] Arthrobacter agilis | 98.15 | NR_026198.1 | Rhizosphere and phyllosphere | [32,33] | |
| [J53] Arthrobacter oryzae | 99.14 | NR_041545.1 | Paddy soil | [34] | |
| [J33] Arthrobacter subterraneus | 99.07 | NR_043546.1 | Subsurface water | [35] | |
| [J43] Dietzia lutea | 99.27 | NR_116462.1 | Rhizosphere | [19] | |
| [J45] Georgenia satyanarayana | 99.93 | NR_117051.1 | Soda lake | [36] | |
| [J8] Kocuria rosea | 99.64 | NR_044871.1 | Rhizosphere | [37] | |
| [J29] Pseudokineococcus basanitobsidens | 98.35 | NR_158070.1 | Volcanic rock | [38] | |
| [J52] Salinibacterium xinjiangense | 97.84 | NR_043893.1 | Glacier | [39] | |
| Firmicutes | [J46] Bacillus fermenti | 98.53 | NR_163641.1 | Indigo fermentation liquid | [40] |
| [J23] Bacillus frigoritolerans | 99.86 | NR_117474.1 | Rhizosphere | [41,42] | |
| [J14] Bacillus jeotgali | 99.65 | NR_025060.1 | Fermented seafood | [43] | |
| [J18] Bacillus licheniformis | 99.79 | NR_118996.1 | Soil, rhizosphere, seawater | [44] | |
| [J27] Bacillus megaterium | 99.79 | NR_112636.1 | Soil, seawater, sediment, food, fish | [45] | |
| [J40] Bacillus sinesaloumensis | 98.18 | NR_147383.1 | Stool | [46] | |
| [J37] Bacillus thioparans | 99.79 | NR_043762.1 | Subtropical estuary | [47] | |
| [J21] Brevibacillus halotolerans | 99.72 | NR_156834.1 | Paddy soil | [48] | |
| [J3] Domibacillus robiginosus | 97.91 | NR_108861.1 | Clean room | [49] | |
| [J25] Fictibacillus nanhaiensis | 99.30 | NR_117524.1 | Bioreactor | [50] | |
| [J50] Fictibacillus phosphorivorans | 98.78 | NR_118455.1 | Bioreactor | [50] | |
| [J56] Paenisporosarcina indica | 98.88 | NR_108473.1 | Glacier | [51] | |
Publisher’s Note: MDPI stays neutral with regard to jurisdictional claims in published maps and institutional affiliations. |
© 2022 by the authors. Licensee MDPI, Basel, Switzerland. This article is an open access article distributed under the terms and conditions of the Creative Commons Attribution (CC BY) license (https://creativecommons.org/licenses/by/4.0/).
Share and Cite
Srinivasan, J.; Khadka, J.; Novoplansky, N.; Gillor, O.; Grafi, G. Endophytic Bacteria Colonizing the Petiole of the Desert Plant Zygophyllum dumosum Boiss: Possible Role in Mitigating Stress. Plants 2022, 11, 484. https://doi.org/10.3390/plants11040484
Srinivasan J, Khadka J, Novoplansky N, Gillor O, Grafi G. Endophytic Bacteria Colonizing the Petiole of the Desert Plant Zygophyllum dumosum Boiss: Possible Role in Mitigating Stress. Plants. 2022; 11(4):484. https://doi.org/10.3390/plants11040484
Chicago/Turabian StyleSrinivasan, Jansirani, Janardan Khadka, Nurit Novoplansky, Osnat Gillor, and Gideon Grafi. 2022. "Endophytic Bacteria Colonizing the Petiole of the Desert Plant Zygophyllum dumosum Boiss: Possible Role in Mitigating Stress" Plants 11, no. 4: 484. https://doi.org/10.3390/plants11040484
APA StyleSrinivasan, J., Khadka, J., Novoplansky, N., Gillor, O., & Grafi, G. (2022). Endophytic Bacteria Colonizing the Petiole of the Desert Plant Zygophyllum dumosum Boiss: Possible Role in Mitigating Stress. Plants, 11(4), 484. https://doi.org/10.3390/plants11040484

